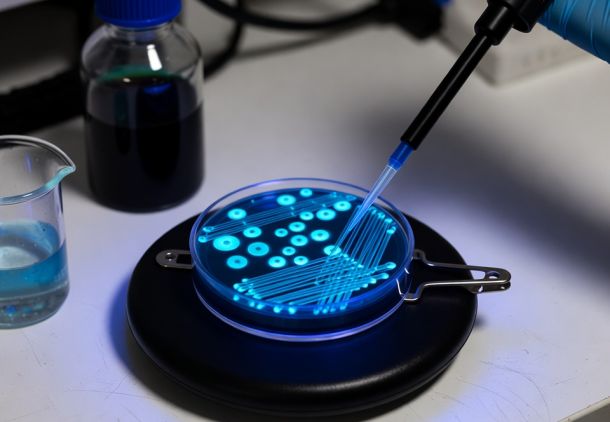

Οι υπηρεσίες μας
Παρέχουμε υψηλής ποιότητας διαγνωστικές υπηρεσίες για την ανίχνευση και την παρακολούθηση λοιμώξεων και άλλων παθολογικών καταστάσεων. Χρησιμοποιούμε εξειδικευμένες τεχνικές και προηγμένο εξοπλισμό για την ανάλυση βιολογικών δειγμάτων, εξασφαλίζοντας γρήγορα και αξιόπιστα αποτελέσματα για τους ασθενείς μας. Η ομάδα μας είναι αφοσιωμένη στην παροχή ακριβούς διάγνωσης και εξατομικευμένης φροντίδας.





Ανοσοφθορισμός
Εξεταστική μέθοδος με σημαντική συμβολή στη διάγνωση και παρακολούθηση διαφόρων νοσημάτων. Ο Ανασοφθορισμός είναι η μέθοδος με την οποία μια ουσία ανιχνεύεται σε κύτταρα ή ιστούς, χρησιμοποιώντας ως ανιχνευτή μια συγγενή ουσία συνασμένη με φθοριόχρωμα. Η ΒιοAνάλυσις χρησιμοποιεί το ειδικό μικροσκόπιο φθορισμού και η εξέταση του ανοσοφθορισμού χρησιμοποιείται για την ανίχνευση και ταυτοποίηση μικροοργανισμών και την ανίχνευση αυτοαντισωμάτων και τη διερεύνηση ρευματικών νοσημάτων. Συμβουλευτείτε το Ρευματολόγο ή τον Παθολόγο σας για το ποιές εξετάσεις διενεργούνται με τη μέθοδο του Ανοσοφθορισμού. Το Μικροβιολογικό Εργαστήριο ΒιοAνάλυσις έχει τη δυνατότητα να πραγματοποιήσει άμεσα όλες τις εξετάσεις με τη μέθοδο του Ανοσοφθορισμού.

Καλλιέργειες
Το τμήμα του Μικροβιολογικού Εργαστηρίου ΒιοAνάλυσις όπου απομονώνονται από τα κλινικά δείγματα (ούρα, κόπρανα, κολπικά – τραχηλικά υγρά, σπέρμα, υγρό τραύματος, σίελος, δερματικές βλάβες κ.τ.λ..) οι υπεύθυνοι Παθογόνοι Μικροοργανισμοί. Στη συνέχεια ελέγχουμε την αντοχή των Μικροοργανισμών αυτών σε μια ευρεία γκάμα αντιβιοτικών. Συμβουλευτείτε το γιατρό σας ο οποίος μπορεί να πάρει το δείγμα ή να σας παραπέμψει στο Μικροβιολογικό Εργαστήριο ΒιοAνάλυσις. Η καλλιέργεια κλινικών δειγμάτων είναι χρονοβόρα διαδικασία και ολοκληρώνεται συνήθως σε 24 με 48 ώρες. Το Μικροβιολογικό Εργαστήριο ΒιοAνάλυσις ειδικεύεται στην καλλιέργεια και ταυτοποίηση σπάνιων μυκήτων (δερματόφυτα) οι οποίοι προσβάλλουν τρίχες, νύχια και δέρμα.
Βιοχημικές Εξετάσεις
Το Μικροβιολογικό Εργαστήριο ΒιοAνάλυσις έχει τη δυνατότητα να δώσει αποτελέσματα εντός δύο ωρών σε μεγάλο αριθμό βιοχημικών εξετάσεων, με τις οποίες ελέγχεται η λειτουργία των οργάνων του σώματος: νεφρική, ηπατική λειτουργία, έλεγχος λιπαιμικού προφίλ (χοληστερίνη, τριγλυκέρια, HDL, LDL, ολικά λιπίδια, απολιποπρωτεϊνη Α, απολιποπρωτεϊνη Β, Lp(a) κ.τ.λ.).Οι Μικροβιολογικές Εξετάσεις που εντάσσονται συμβάλλουν ουσιαστικά στην άμεση διερεύνηση της λειτουργίας του οργανισμού. Οι εξειδικευμένοι και έμπειροι Μικροβιολόγοι μας ακολουθούν τις οδηγίες της Ελληνικής Καρδιολογικής Εταιρείας και της Αμερικανικής Καρδιολογικής Καρδιολογικής Εταιρείας (American Heart Association) για την αξιολόγηση των αποτελεσμάτων και τον προσδιορισμό του αθηρωματικού δείκτη που καταδεικνύει τον κίνδυνο Καρδιαγγειακής Νόσου.


Αιματολογικό - Αιμόσταση
Πραγματοποιούνται οι εξετάσεις δειγμάτων αίματος για μέτρηση σε ειδικό Αιματολογικό Αναλυτή των ερυθρών, λευκών και αιμοπεταλίων και γίνεται έλεγχος αναιμίας μέσω της μέτρησης της αιμοσφαιρίνης και του αιματοκρίτη. Οι ειδικευόμενοι Μικροβιολόγοι ελέγχουν τη μορφολογία των κυττάρων στο υψηλής ευκρίνειας οπτικό μικροσκόπιο χρησιμοποιώντας ειδικές χρώσεις προς αποκλεισμό αιματολογικών παθήσεων. Αιμόσταση είναι το σύνολο των μηχανισμών που προκαλεί φυσιολογικά την πήξη του αίματος και την αρχική επούλωση τραυμάτων. Ειδικευόμαστε στις μεθόδους μέτρησης των παραγόντων της πήξεως (π.χ. Πρωτεΐνη C, Πρωτεΐνη S, Ινωδογόνο). Πραγματοποιείται η μέτρηση του χρόνου προθρομβίνης, το αποτέλεσμα της οποίας βοηθά το γιατρό σας να ρυθμίσει τη δόση των αντιπηκτικών σας φαρμάκων. Οι εξετάσεις αυτές είναι πολύ ευαίσθητες και απαιτούν εξειδικευμένη τεχνική και εμπειρία διότι οποιοδήποτε λανθασμένο αποτέλεσμα μπορεί να παρασύρει τον κλινικό γιατρό σε χορήγηση λανθασμένης δοσολογίας με αποτέλεσμα αιμορραγία ή αντίθετα σε υπερπηκτικό σύνδρομο δηλαδή θρόμβωση.
Ανοσολογικές Εξετάσεις
Καθημερινά ο ανθρώπινος οργανισμός βομβαρδίζεται από πλήθος μικροοργανισμών όπως οι ιοί, τα βακτήρια, τα παράσιτα και οι μύκητες, αλλά και διάφορα χημικά μόρια, ακόμη και τη γύρη των λουλουδιών. Ο οργανισμός αντιδρά με μια σειρά κυτταρικών και μοριακών διεργασιών που συνιστούν την ανοσιακή απάντηση. Υπάρχει πλήθος ανοσολογικών εξετάσεων μέσω των οποίων ελέγχεται αυτή η ανοσιακή απάντηση του οργανισμού μας. Το Μικροβιολογικό Εργαστήριο ΒιοAνάλυσις διαθέτει εξειδικευμένο Ανοσολογικό Αναλυτή υψηλής ταχύτητας και ακριβείας στον οποίο πραγματοποιούμε άνω των 80 διαφορετικών Ανοσολογικών Εξετάσεων με παράδοση αποτελεσμάτων σε 24 έως 48 ώρες. Ενδεικτικά αναφέρουμε: Ηπατίτιδα Α, Ηπατίτιδα Β, Ηπατίτιδα C, HIV – AIDS, CMV, Ερυθρά, Τοξόπλασμα, Λοιμώδης Μονοπυρήνωση, Αλλεργιογόνα – Rast.


Ορμονολογικές Εξετάσεις
Το Μικροβιολογικό Εργαστήριο ΒιοAνάλυσις διαθέτει σύγχρονους Ορμονολογικούς Αναλυτές υψηλής ακριβείας και ταχύτητας οι οποίοι μας δίνουν τη δυνατότητα να παραδίδουμε αποτελέσματα σε εξετάσεις Θυροειδούς, Ορμόνες Γονιμότητας, εξετάσεις Προγεννητικού Ελέγχου, Καρκινικούς Δείκτες, Τέστ Εγκυμοσύνης, εντός δύο ωρών. Η ΒιοAνάλυσις συνεργάζεται με Κέντρα Εξωσωματικής Γονιμοποίησης κατά την διάρκεια της προετοιμασίας της ασθενούς, παραδίδοντας καθημερινά, εντός δύο ωρών, αποτελέσματα Οιστραδιόλης Ε2, Προγεστερόνης PRG, FSH, LH.

